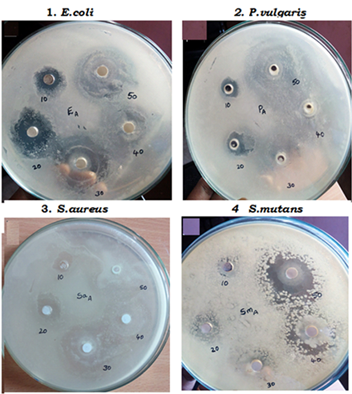

Int J Pharm Pharm Sci, Vol 10, Issue 1, 32-35Original Article
SYNTHESIS, CHARACTERIZATION AND ANTIBACTERIAL ACTIVITY OF ALUMINIUM OXIDE NANOPARTICLES
MANYASREE D.a, KIRANMAYI P.a*, RAVI KUMAR R. V. S. S. N.b
aDepartment of Biochemistry, Acharya Nagarjuna University, Nagarjuna Nagar 522510, India, bDepartment of Physics, Acharya Nagarjuna University, Nagarjuna Nagar 522510, India
Email: kiranmayikodali@rediffmail.com
Received: 10 Jun 2017 Revised and Accepted: 22 Nov 2017
ABSTRACT
Objective: In the present study, synthesized alumina (Al2O3) nanoparticles were characterized and their antibacterial activity against gram positive and gram negative organisms were studied.
Methods: The synthesis was carried out by coprecipitation method using aluminium sulfate and NaOH as precursors. The synthesized aluminium oxide nanoparticles were characterized by using X-ray diffraction (XRD), Fourier transforms infrared spectroscopy (FT-IR) and scanning electron microscope (SEM) with Energy Dispersive X-ray Analysis (EDX) techniques. Besides, this study determines the antibacterial activity and minimum inhibitory concentration (MIC) of Al2O3 nanoparticles against gram-positive (Staphylococcus aureus and Streptococcus mutans) and gram-negative (E. coli and Proteus vulgaris) bacteria.
Results: The average crystallite size of Al2O3 nanoparticles was found to be 35 nm by X-ray diffraction. FT-IR spectrum exhibited the peaks at 615 and 636 were assigned to the aluminium oxide stretching. The EDX measurements indicated the presence of Al along with O peaks. It indicates the purity of the sample. The antimicrobial assay revealed that E. coli showed a maximum zone of inhibition (39 mm) at 50 mg/ml concentration of Al2O3 nanoparticles.
Conclusion: In conclusion, aluminium oxide is a good antibacterial agent against both gram positive and gram-negative organisms.
Keywords: Al2O3 nanoparticles, XRD, FTIR, SEM, EDX, Antibacterial activity and MIC
© 2018 The Authors. Published by Innovare Academic Sciences Pvt Ltd. This is an open access article under the CC BY license (http://creativecommons.org/licenses/by/4.0/)
DOI: http://dx.doi.org/10.22159/ijpps.2018v10i1.20636
INTRODUCTION
Nanotechnology is evolving as a rapidly developing area with its application in science and technology for the purpose of engineering new materials at the nanoscale level [1]. Nanoparticles possess different chemical properties when compared to bulk types of similar chemical composition [2]. Metal oxide nanoparticles have exhibited better durability, lower toxicity, higher stability and selectivity when compared to organic compounds [3]. Moreover, the size of such particles is responsible for the changes in their basic physical and chemical properties. These particles exhibits remarkable applications in catalysis, diagnosis, drug delivery, water treatment, cosmetics, semiconductors, sensing and solid oxide fuels [4, 5]. Aluminium oxide nanoparticles have important applications in ceramic industry [6] and can be used as an abrasive material, in heterogeneous catalysis as an absorbent, as a biomaterial and as reinforcements of metal-matrix composites [7, 8].
In recent years, a rapid increase in microbes that are resistant to conventionally used antibiotics has been observed [9]. A reduction in the particle size from ∼10 µm to 10 nm will increase the contact surface area by 109. In this context nanoscale materials have emerged up as novel antimicrobial agents owing to their high surface area to volume ratio and its unique chemical and physical properties [10]. Such a large contact surface is expected to enhance the extent of bacterial elimination [11]. Reactive groups on a particle surface are likely to modify its biological activity. Therefore, changes in surface chemistry and the type of metal oxide nanoparticle are important in terms of microbial toxicity issues [12]. Alumina nanoparticles are thermodynamically stable particles over a wide temperature range. They are corundum like structure with oxygen atoms adopting hexagonal close packing with alumina ions filling two-thirds of the octahedral sites in the lattice [13]. To the best of our knowledge, there is not much significant research work on the antibacterial properties of alumina nanoparticles. So an attempt has been made to investigate the antibacterial activity and minimum inhibitory concentration of Al2O3 nanoparticles synthesized by co-precipitation method.
MATERIALS AND METHODS
Synthesis of alumina nanoparticles
The alumina nanoparticles were prepared by coprecipitation method using aluminium sulfate and sodium hydroxide precursors. Aluminium sulfate, 0.1M, was dissolved in distilled water and the solution was kept under constant stirring using a magnetic stirrer for one hour. After complete dissolution of aluminium sulfate, 0.2M of sodium hydroxide solution was added. The obtained white creamy solution was allowed to settle for an overnight and the supernatant was then discarded carefully. The precipitate was washed several times using distilled water, then dried at 80 °C for overnight. During drying, complete conversion of aluminium hydroxide into alumina takes place.
Characterization
The X-ray diffraction (XRD) of a powdered sample of Al2O3 was recorded using an XRD-6100 diffractometer (Shimadzu), and the patterns were recorded with 1.54060 Å Cu Kα radiation. Molecular analysis of the samples was performed by Fourier transform infrared spectroscopy (FT-IR) using IR Affinity-1s (Shimadzu) spectrometer, recorded in the wave number range of 400–4,000 cm‑1. Morphological study of the nanoparticles was carried out with a scanning electron microscope (SEM) (EVO 18 carlzeiss).
The antibacterial activity of the Al2O3 nanopowder was determined by agar well diffusion method [1] against four microorganisms, E. coli (MCC 2412) and Staphylococcus aureus (MCC2408) were procured from MCC, Pune, India and Proteus vulgaris (MTCC 426) and Streptococcus mutans (MTCC 497) were procured from MTCC, Chandigarh, India. Once the medium was solidified, a suspension of each sample for testing microorganism diluted prior to 10-1, 10-2and 10-3 (1 ml of 108 cells/ml) was spread on a solid agar medium in petri plates (E. coli and Proteus vulgaris-Nutrient agar medium; Staphylococcus aureus-Trypticase soy yeast extract agar medium; Streptococcus mutans–Brain heart infusion agar). The wells were prepared by using sterile cork borer (6 mm). Each well was filled with different concentrations of nanomaterial ranging from 10-50 mg/ml. The plates were incubated at 37 ° C for 24 h. Antibacterial activity was evaluated by measuring the inhibition zone against test microorganisms.
Minimum inhibitory concentration
The lowest concentration of material that inhibits the growth of an organism [14] is defined as Minimum inhibitory concentration (MIC). MIC was determined by using the broth dilution method. A series of 4 test tubes were taken add 10 ml of media and a loop full of culture to all the test tubes and finally add 2 mg/ml, 4 mg/ml, 6 mg/ml and 8 mg/ml of nanoparticle suspension to each test tube. The test tube without bacterial suspension is considered as control. Keep the test tubes for overnight incubation at 37 °C temperature. Read the absorbance at 600 nm using a spectrophotometer. MIC is where the absorbance value of the sample equals to or near to control [15].
RESULTS AND DISCUSSION
X-ray diffraction studies
Fig. 1 shows the diffraction peaks of the aluminium oxide nanoparticles. XRD pattern of the synthesized Al2O3 nanopowder is in monoclinic structure and theta (θ) phase. The observed diffraction peaks and relative intensities of all diffraction peaks matches well with the reported values (JCPDS # 35-0121). Powder XRD pattern of θ-Al2O3 nanopowder exhibited diffraction peaks at 2θ = 18.96 °, 32.08 °, 38.57 °, 47.98 °, 50.74 °, 52.49 °, 59.94 °, 61.25 °, 65.25 ° and 67.46 ° which are associated with (102), (200), (104), (006), (015), (304), (313), (306), (017) and (217) planes, respectively and are assigned in table 1. The size of Al2O3 nanoparticles was obtained by Debye-Scherrer’s formula given by the equation:
D = 0.9λ/βcosθ
Where, D-the crystal size, the λ-the wavelength of the X-ray radiation, θ is the diffraction angle, and β-the full width half maximum height [16]. The calculated average crystallite size was found to be 35 nm. The evaluated cell parameters a = 0.5681, b = 0.2890, and c = 1.1776 nm are in close agreement with the reported values.

Fig. 1: X-ray powder diffraction patterns of the Al2O3 nanoparticles
Table 1: X-ray diffraction patterns of Alumina Nano powder
| Observed 2θ | Standard 2θ | h k l |
| 18.96 | 19.55 | 1 0-2 |
| 32.08 | 32.80 | 2 0 0 |
| 38.57 | 38.95 | 1 0 4 |
| 47.98 | 47.66 | 0 0 6 |
| 50.74 | 50.66 | 0 1 5 |
| 52.49 | 52.79 | 3 0-4 |
| 58.28 | 58.77 | 3-1-1 |
| 59.94 | 59.47 | 3 1-3 |
| 61.25 | 61.48 | 3 0-6 |
| 65.25 | 65.44 | 0 1 7 |
| 67.46 | 67.47 | 2 1-7 |
Fourier transform infrared spectroscopy (FT-IR) studies
FT-IR spectroscopy is useful in measuring the absorption of IR radiations by a sample, and the results are shown by means of a wavelength. The evaluation of the IR spectrum includes the correlation of the absorption bands (vibrational bands) and the chemical compounds in the sample [17]. FTIR spectrum of synthesized aluminium oxide nanoparticles was shown in fig. 2. The characteristic peaks of aluminium oxide were depicted in table 2. The Peaks at 615 and 636 are assigned to the aluminium oxide stretching [13]. The peak at 1127 indicates the triply degenerative vibrational mode of sulphate ion. The peaks at 1646 and 3526 are assigned to the bending and stretching vibration mode of a water molecule.

Fig. 2: FT-IR spectrum of aluminium oxide nanoparticles
Table 2: Assignment of FT-IR bands of alumina nanopowder
| S. No. | Wavenumber (cm1) | Band assignment |
| 1 | 615 | Al-O stretching |
| 2 | 636 | Al-O stretching |
| 3 | 1127 | Triply degenerative ν3 mode of SO4-2ion |
| 4 | 1646 | Bending vibration of water molecule |
| 5 | 3526 | Stretching vibration of water molecule |
Scanning electron microscope and energy dispersive X-ray spectroscopy analysis
Fig. 3 depicts the surface morphology of aluminium oxide was irregular spherical shaped [13]. The grain size determined by XRD is different from the grain sizes observed from SEM due to segregation among the crystal nucleus. The chemical composition of aluminium oxide nanomaterial was examined using EDX (Energy Dispersive X-ray spectroscopy) in (fig. 4). Quantitative measuring results obtained from EDX analysis reflect the purity of aluminium oxide. The other weaker signal of K is owing to use precursor salts for the synthesis of nanoparticles. It indicates the purity of the sample. The EDX measurements indicate the presence of Al along with O peaks.

Fig. 3: SEM images of aluminium oxide nanomaterial

Fig. 4: EDX spectrum of aluminium oxide Nano powder
Antibacterial activity of the Al2O3 Nano powder
The antibacterial activity of aluminium oxide nanoparticles was tested against various bacterial strains E. coli (MCC 2412), Proteus vulgaris (MTCC 426), Staphylococcus aureus (MCC 2408) and Streptococcus mutans (MTCC 497). Fig. 5 represents the antibacterial activity of Al2O3 nanoparticles for various bacteria in a well diffusion technique. The results indicated that Al2O3 nanoparticles synthesized by co-precipitation method showed effective antibacterial activity against pathogenic bacteria. The results showed that the inhibitory effect of Al2O3 nanoparticles increased with the increase in concentration. The diameter of inhibitory zone shows the degree of susceptibility of microorganisms. The strain susceptible to Al2O3 nanoparticles exhibited a larger zone of inhibition (E. coli), whereas resistant strain exhibit a smaller zone of inhibition (Proteus vulgaris) [18].
Fig. 5: Antibacterial activities of aluminium oxide nanoparticles against bacteria using agar well diffusion method, the fig. showed (1) E. Cali (2) Proteus vulgaris (3) Staphylococcus aureus (4) Streptococcus mutans
Table 3: Inhibition zones at different concentrations against two gram-positive and two gram-negative organisms
| S. No. | Name of the organism | Mean zones of inhibition [mm]±SD [n=2] | ||||
| 10 mg/ml | 20 mg/ml | 30 mg/ml | 40 mg/ml | 50 mg/ml | ||
| 1 | E. coli | 9±0.20 | 18±0.25 | 27±0.25 | 31±0.10 | 39±0.35 |
| 2 | Proteus vulgaris | 5±0.30 | 10±0.40 | 15±0.45 | 20±0.20 | 26±0.45 |
| 3 | Staphylococcus aureus | 6±0.15 | 12±0.10 | 18±0.35 | 23±0.25 | 29±0.40 |
| 4 | Streptococcus mutans | 8±0.35 | 14±0.35 | 19±0.30 | 25±0.10 | 30±0.30 |
Determination of minimum inhibitory concentration
The results showed significant MIC values between 2 mg/ml to 8 mg/ml concentration. Proteus vulgaris showed MIC at 8 mg/ml, streptococcus mutans showed MIC at 6 mg/ml and staphylococcus aureus and E. coli showed MIC at 4 mg/ml for aluminium oxide nanopowder and were shown in table 4. Determination of the MIC is important in diagnostic laboratories because it helps in confirming resistance of a microorganism to an antimicrobial agent and it monitors the activity of new antimicrobial agents.
Table 4: MIC values of aluminium oxide by broth dilution method
| S. No. | Name of the organism | MIC (mg/ml) |
| 1 | E. coli | 4 |
| 2 | Proteus vulgaris | 8 |
| 3 | Streptococcus mutans | 6 |
| 4 | Staphylococcus aureus | 4 |
CONCLUSION
The Co-precipitation method has been used to synthesize aluminium oxide nanoparticles and shows a monoclinic structure with theta (θ) phase. The XRD result confirmed aluminium oxide has the crystallite size of 35 nm. The aluminium oxide nanoparticles showed their antibacterial properties on both gram positive and gram negative bacterial strains. Due to the formation of the zone of inhibition, we can conclude that aluminium oxide is a good antibacterial agent.
AUTHORS CONTRIBUTIONS
These authors contributed equally to this work
CONFLICT OF INTERESTS
All authors have none to declare
REFERENCES
Ravi Chandrika K, Kiranmayi P, Ravikumar RVSSN. Synthesis, characterization and antibacterial activity of ZnO nanoparticles. Int J Pharm Sci 2012;4:336-8.
Warheit DB. Toxicological highlight how meaningful are the results of nanotoxicity studies in the absence of adequate material characterization. Toxicol Sci 2008;101:183–5.
Slavica Stankic, Sneha Suman, Francia Haque, Jasmina Vidic. Pure and multi metal oxide nanoparticles: synthesis, antibacterial and cytotoxic properties. J Nanobiotechnol 2016; 14:73.
Corr SA. Metal oxide nanoparticles. Nanoscience 2013;1:180–234.
Haddad PS, Seabra AB. Biomedical applications of magnetic nanoparticles. In: Martinez AI. editor. Iron oxides: structure, properties and applications. New York; Nova Science Publishers; 2012. p. 165–88.
Hench LL. Bioceramics: from concept to clinic. J Am Ceram Soc 1991;74:1487-510.
Travitzky N, Kumar P, Sandhage KH, Janssen R. Claussen N. Rapid synthesis of Al2O3 reinforced Fe-Cr-Ni composites. Mater Sci Eng A 2003;344:245-52.
Ganguly P, Poole Warren J. In situ measurement of reinforcement stress in an aluminium-alumina metal matrix composite under compressive loading. Mater Sci Eng 2003:352:46-54.
Goffeau A. Drug resistance: the fight against fungi. Nature 2008;452:541–2.
Ravi Chandrika K, Kiranmayi P. Ravikumar RVSSN. Role of zinc oxide nanoparticles enhancing the antibacterial activity of antibiotics. Asian J Pharm Clin Res 2012;4:97-9.
Ibrahim Mohamed Hamouda. Current perspectives of nanoparticles in medical and dental biomaterials. J Biomed Res 2012;26:143-51.
Sadiq MI, Chowdhury B, Chandrasekaran N, Mukherjee A. Antimicrobial sensitivity of Escherichia coli to alumina nanoparticles. Nanomed: Nanotech Biol Med 2009;5:282–6.
Neethumol Varghese, Manjusha Hariharan, Benny Cherian A, Sreenivasan PV, Jenish Paul, et al. PVA-Assisted synthesis and characterization of nano α–alumina. Int J Sci Res 2014;4:1-4.
Qi L, Xu Z, Jiang X, Hu C, Zou X. Preparation and antibacterial activity of chitosan nanoparticles. Carbohydr Res 2004; 339:2693–700.
Ruparelia JP, Arup KC, Siddhartha P, Duttagupta, Suparna M. Strain specificity in antimicrobial activity of silver and copper nanoparticles. Acta Biomater 2008;4:707–16.
Vijayalakshmi R, Rajendran V. Synthesis and characterization of nano-TiO2 via different methods. Arch Appl Sci Res 2012;4:1183–90.
Dobrucka R, Długaszewska J. Biosynthesis and antibacterial activity of Zno nanoparticles using Trifolium pratense flower extract. Saudi J Biol Sci 2016;23:517-23.
Geoprincy G, Nagendhra N, Gandhi S, Renganathan. Novel antibacterial effects of alumina nanoparticles on Bacillus cereus and Bacillus subtilis in comparison with antibiotics. Int J Pharm Pharm Sci 2012;4:544-8.